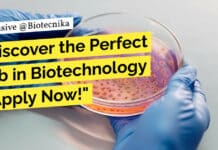
Discover the Perfect Job in Biotechnology – Apply Now at Syngene! "Discover the Perfect Job in Biotechnology - Apply Now!"

Discover the Perfect Job in Biotechnology – Apply Now at Syngene!
Biotechnology Associate Jobs Syngene - Biochem Apply Online
Designation: Senior Research Associate
Job Location: BANGALORE
Reporting to: Senior Principal Scientist
Job ID: 55195
Job Grade: 9 II
Syngene International Ltd....
Exciting Opportunity: Join AIIMS Bhopal as a Senior Research Fellow and Predict Methotrexate Responsiveness...
AIIMS Bhopal SRF Recruitment - Life Sciences Apply
Senior Research Fellow (SRF) - AIIMS Bhopal
Applications are invited from eligible candidates for a contractual post of...
Calling all Life Science enthusiasts! AIIMS Bhopal Is Hiring For Research Vacancy!
AIIMS Bhopal Research Vacancy For Life Sciences: Applications Invited
Applications are invited from eligible candidates for contractual post of
Junior Research Fellow for the project entitled...
Freshers Job Alert! Join Clarivate as an Associate Content Editor – Patent Analyzing!
Clarivate Freshers Jobs - Apply For Patent Analyzing Role
Associate Content Editor - Patent Analyzing
Join our Abstraction team and enhance the research value of Patent...
CSIR NET Dec 2023 Exam Analysis – Register & Get Rs 499 Worth Gift...
CSIR NET Exam Analysis - CSIR NET Dec 2023
Congratulations, brave minds! You've tackled one of the toughest exams, the CSIR NET Dec 2023, and...
Attention Biology Enthusiasts! Don’t Miss Out on this Exciting JRF Job at MAHE Manipal...
MAHE Manipal Genetics JRF - Biological Sciences Apply
Junior Research Fellow - Biological Sciences
Manipal Academy of Higher Education (MAHE) is now hiring for the position...
Breaking News: High-Paying Medical Writing Vacancy at Syneos Health – Apply Now!
Syneos Health Medical Writing Vacancy For Life Sciences
Syneos Health® is a leading fully integrated biopharmaceutical solutions organization built to accelerate customer success. We translate...
Land Your Dream Job in Clinical Research – Apply Now at Parexel, Biological Sciences...
Parexel Clinical Research Job For Biological Sciences, Apply Online
Senior Clinical Research Associate
India-Bengaluru-Remote
Posted 5 Days Ago
Job Requisition ID: R0000007021
About Parexel
At Parexel, we all share the...
Manipal Insitute of Regenerative Medicine, MAHE Workshop on Innovations in Regenerative Medicine: Advanced Tissue...
INNOVATIONS IN REGENERATIVE MEDICINE: ADVANCED TISSUE ENGINEERING TECHNIQUES WORKSHOP
19th & 20th January 2024
Venue: Manipal Institute of Regenerative Medicine, MAHE, Bengaluru
Objective: To understand the latest...
Unbelievable Opportunity! High-Paying Research Job at JNCASR – Calling all Biochemists!
Mol Bio JNCASR Research Job - Biochem Can Also Apply
Advt. No.: M.Sc Int Bio/2023/01
Date:21/12/2023
Applications are invited for a temporary position of Research Associate...
Exciting Job Opportunity in Life Sciences at RCB Faridabad! Apply Now and Contribute to...
Life Sciences MSc Project-JRF Job at RCB Faridabad, Apply Online
Advt. No. 45/Project/2023/HR
Interview for Project-JRF position
Title of Project: Identification of Small Molecule Inhibitors of SARS-COV-2...
Rare Opportunity: Join the Indian Army in Saving Endangered Species at BNHS – MSc...
BNHS Life Sciences Research Job - Applications Invited
Job description for recruitment of Research Fellow
Bombay Natural History Society (BNHS) is a leading research organization in...
Virtual Walk In Drive at Intas Pharmaceuticals – Exciting Job Opportunities in the Biotech...
Opportunities with Intas Pharmaceuticals
Intas Pharmaceuticals is a leading global pharmaceutical company that specializes in the development and manufacturing of high-quality generic and biosimilar products....
Want to Work as a Clinical Data Coder? Check out this Exciting Job Opportunity...
IQVIA Clinical Data Coder for Life Sciences, Apply Online
Company: IQVIA
Job Title: Clin Data Coder 1
Location: Bengaluru, India
Employment Type: Full time
Job ID: R1392230
Job Overview
IQVIA is...
Breaking: Exclusive Job Opening for Quality Specialist in Mumbai – Apply Now!
IFF Quality Specialist Job Opening, Apply Online
Job Description
Are you inspired to contribute your expertise to a global leading Ingredients organization? We are a global...